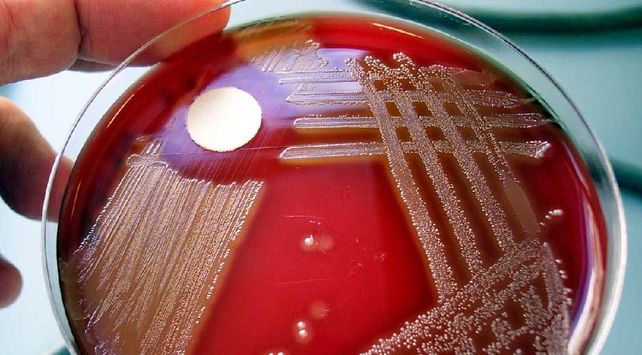
Salud advirtió que la bacteria estreptococo pyogenes es infrecuente

El Ministerio de Salud provincial advirtió, ante la presencia de la bacteria estreptococo pyogenes, que estas infecciones son infrecuentes y recordó que con la consulta oportuna, el diagnóstico y el tratamiento adecuado se logra una evolución favorable.
Salud advirtió que la bacteria estreptococo pyogenes es infrecuente

Por Loreley Duré
El estreptococo de grupo A (EGA) es una bacteria que se encuentra a menudo en la garganta y en la piel. Las personas pueden llevar dicha bacteria y no tener síntomas de enfermedad. La mayoría de las infecciones son relativamente leves, tales como “infección de garganta”. En ocasiones raras, esta bacteria puede ocasionar otras enfermedades agudas más graves.
LEER MÁS: La bacteria letal se cobró otra víctima
Esta bacteria se propaga mediante contacto directo con secreciones de la nariz o la garganta de las personas infectadas, o mediante contacto con las heridas o lesiones de la piel. El tratamiento de las personas infectadas con un antibiótico durante 24 horas o más tiempo elimina por lo general su capacidad de propagar la bacteria.
Las infecciones invasivas ocurren cuando la bacteria traspasa las defensas de la persona infectada. Esto puede suceder cuando se presentan lesiones en la piel que permiten a las bacterias introducirse en el tejido o cuando la capacidad de una persona para combatir la infección disminuye debido a enfermedades crónicas o a una afección que repercute en el sistema inmunológico.
Desde el Ministerio recomiendan realizar la consulta urgente si se presentan estos síntomas: fiebre con temblores, palidez marcada y/o coloración azulada de labios y extremidades, manchas rosadas violáceas en la piel, dificultad para respirar que se incrementa, rechazo de líquidos y alimentos, cuadros confusionales, sueño o irritabilidad excesiva.
Sobre la sepsis
Se la conoce también como infección generalizada. Es una enfermedad en la cual el cuerpo tiene una respuesta inflamatoria intensa frente a distintos microorganismos o sustancias liberadas por los mismos.
LEER MÁS: Qué cuidados ante la sospecha de una infección bacteriana infantil
En consecuencia, pueden ocurrir cambios que dañen varios sistemas y órganos dejando de funcionar correctamente. Estas infecciones son infrecuentes, es importante la consulta oportuna para que, con el diagnóstico y el tratamiento adecuado, se pueda lograr una evolución favorable.
Los síntomas pueden ser causados por los gérmenes y/o los productos químicos que libera el cuerpo. Una infección bacteriana en cualquier lugar del cuerpo puede evolucionar a la sepsis. De estos, los más comunes son meningitis, neumonías y peritonitis.
Síntomas y diagnóstico
Una persona con sepsis siempre lucirá muy enferma. Existe una caída de la presión arterial que causa el shock y los órganos más importantes funcionan mal debido a una circulación insuficiente. Los síntomas incluyen fiebre, dificultad para respirar, baja presión arterial, ritmo cardíaco acelerado y confusión mental. También se puede presentar sangrado o hematomas
A través de los síntomas y signos que se presentan, se realizan distintos estudios tratando de identificar la causa de la infección.
Tratamiento y pronóstico
Siempre se indica internación en unidad de cuidados intensivos (UCI) con antibióticos y otras drogas. Puede requerirse diálisis si hay insuficiencia renal y ventilación mecánica (respirador) si se presenta insuficiencia pulmonar.
Son cuadros graves, sobre todo en personas con un sistema inmunitario debilitado o con una enfermedad prolongada (crónica). Si la consulta es oportuna y con los cuidados adecuados, la sobrevida es posible.






















